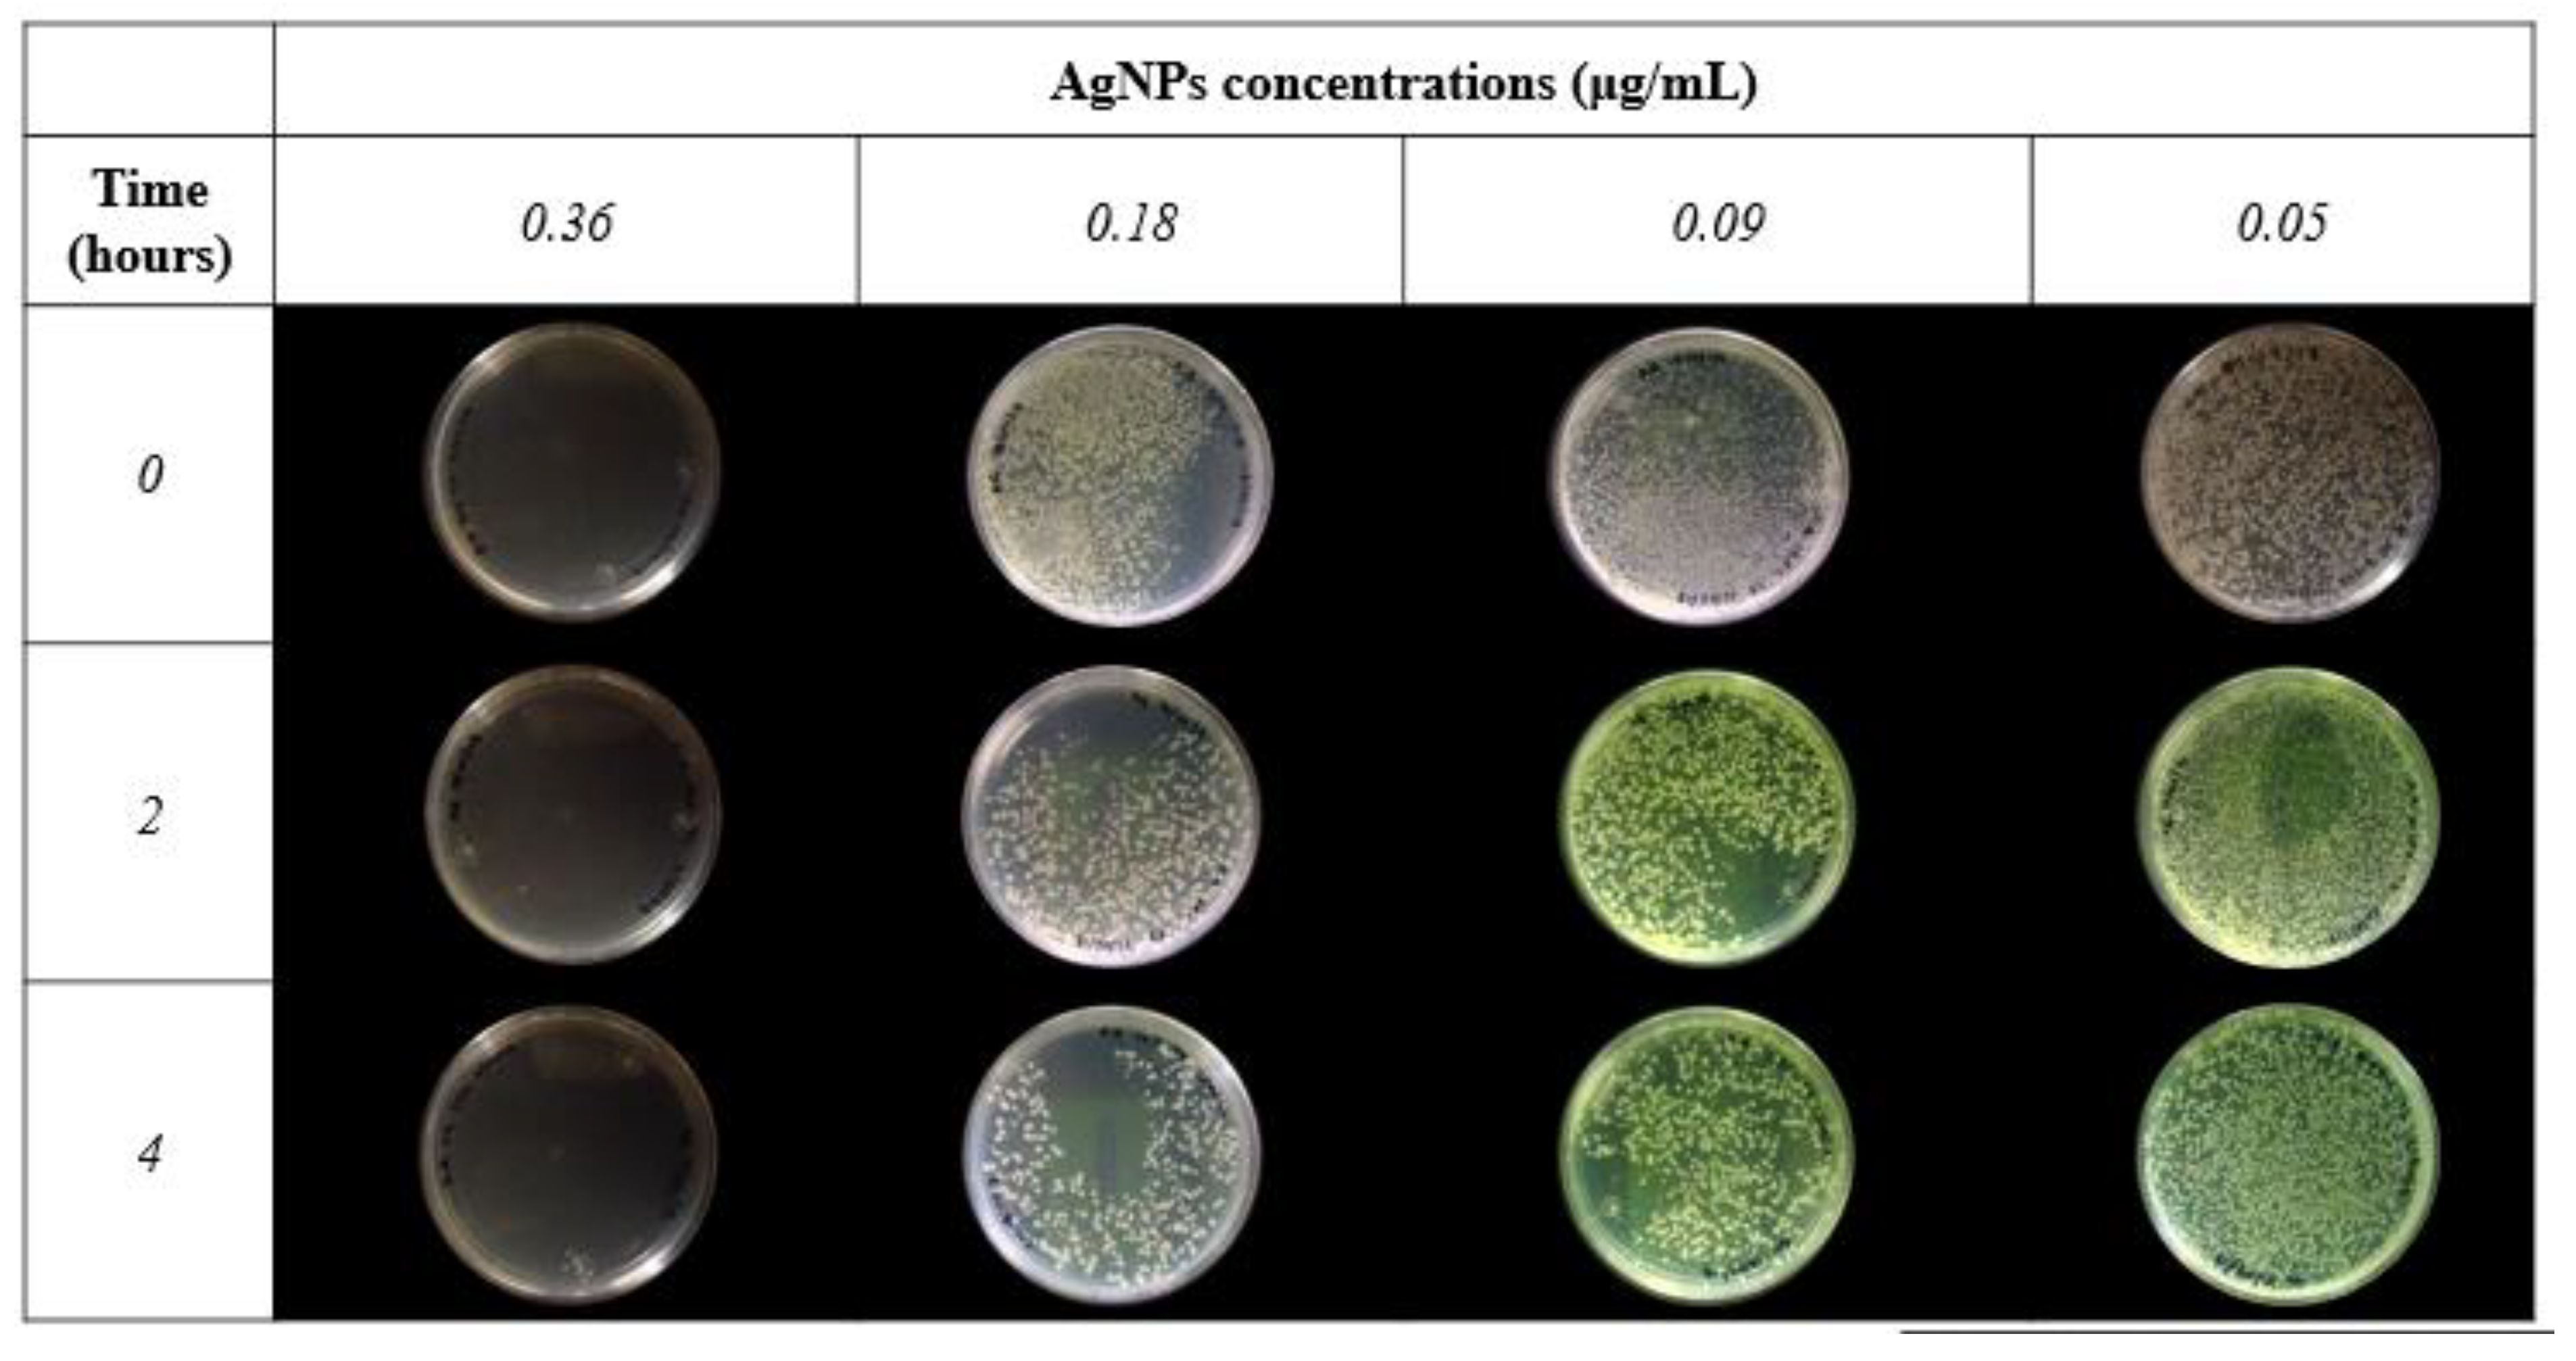
Crystals 10 00395 g006

Characterization of Silver Nanoparticles Obtained by a Green Route and Their Evaluation in the Bacterium of Pseudomonas aeruginosa
Abstract
1. Introduction
2. Materials and Methods
2.1. Strain and Growth Culture
2.2. Extract Preparation
2.3. Synthesis of Silver Nanoparticles (AgNPs)
2.4. Nanoparticles Characterization
2.5. Evaluation of Antimicrobial Activity (Minimum Inhibitory Concentration MIC)
2.6. Antibacterial Sensitivity
3. Results and Discussion
4. Conclusions
Author Contributions
Funding
Acknowledgments
Conflicts of Interest
References
- Staggers, N.; Mckasky, T.; Braselton, N.; Kennedy, R. Nanotechnology: The coming revolution and its implications for consumers, clinicians, and informatics. Nurs. Outlook 2008, 56, 268–274. [Google Scholar] [CrossRef] [PubMed]
- Hochella, M.F. Nanoscience and technology: The next revolution in the Earth sciences. Earth Planet. Sci. Lett. 2002, 203, 593–605. [Google Scholar] [CrossRef]
- Beumer, K. Broadening nanotechnology’s impact on development. Nat. Nanotechnol. 2016, 11, 398–400. [Google Scholar] [CrossRef] [PubMed]
- Lieber, C.M.; Gao, R.; Strehle, S. Nanoscale Sensors for Intracellular and Other Applications. American Patent No. U.S. 9638717 B2, 2 May 2017. [Google Scholar]
- Jiang, H.; Moon, K.; Zhang, Z.; Pothukuchi, S.; Wong, C.P. Variable frequency microwave synthesis of silver nanoparticles. J. Nanopart. Res. 2006, 8, 117–124. [Google Scholar] [CrossRef]
- Laksee, S.; Puthong, S.; Teerawatananond, T.; Palaga, T.; Muangsin, N. Highly efficient and facile fabrication of monodispersed Au nanoparticles using pullulan and their application as anticancer drug carriers. Carbohydr. Polym. 2017, 173, 178–191. [Google Scholar] [CrossRef]
- Parashar, U.K.; Saxena, S.P.; Srivastava, A. Bioinspired synthesis of silver nanoparticles. Dig. J. Nanomat. Biostruct. 2009, 4, 159–166. [Google Scholar]
- Rashid, R.; Murtaza, G.; Zahra, A. Gold Nanoparticles: Synthesis and Applications in Drug. Trop. J. Pharm. Res. 2014, 13, 1169–1177. [Google Scholar]
- Anand, K.; Tiloke, C.; Naidoo, P.; Chuturgoon, A.A. Phytonanotherapy for management of diabetes using green synthesis nanoparticles. J. Photochem. Photobiol. B 2017, 173, 626–639. [Google Scholar] [CrossRef]
- Handy, R.D.; Henry, T.B.; Scown, T.M.; Johnston, B.D.; Tyler, C.R. Manufactured nanoparticles: Their uptake and effects on fish-a mechanistic analysis. Ecotoxicology 2008, 17, 396–409. [Google Scholar] [CrossRef]
- Biswas, P.; Wu, C.Y. Critical review: Nanoparticles and the environment. J. Air Waste Manag. Assoc. 2005, 55, 708–746. [Google Scholar] [CrossRef]
- Nowack, B.; Bucheli, T.D. Occurrence, behaviour and effects of nanoparticles in the environment. Environ. Pollut. 2007, 150, 5–22. [Google Scholar] [CrossRef] [PubMed]
- Sajid, M.; Llyas, M.; Basheer, C. Impact of nanoparticles on human and environment: Review of toxicity factors, exposures, control strategies, and future prospects. Environ. Sci. Pollut. Res. Int. 2015, 22, 4122–4143. [Google Scholar] [CrossRef]
- Sastry, M.; Ahmad, A.; Khan, M.I.; Kumar, R. Microbial Nanoparticle Production. Nanobiotechnology, Concepts, Applications and Perspectives; Niemeyer, C.M., Mirkin, C.A., Eds.; Wiley-VCH: Weinheim, Germany, 2004; pp. 126–135. [Google Scholar]
- Bhattacharya, D.; Rajinder, G. Nanotechnology and potential of microorganisms. Crit. Rev. Biotechnol. 2005, 25, 199–204. [Google Scholar] [CrossRef]
- Mohanpuria, P.; Rana, N.K.; Yadav, S.K. Biosynthesis of nanoparticles: Technological concepts and future applications. J. Nanopart. Res. 2008, 10, 507–517. [Google Scholar] [CrossRef]
- Tippayawat, P.; Phromviyo, N.; Boueroy, P. Green synthesis of silver nanoparticles in aloe vera plant extract prepared by a hydrothermal method and their synergistic antibacterial activity. PeerJ 2016, 19, e2589. [Google Scholar] [CrossRef] [PubMed]
- Bagherzade, G.; Tavakoli, M.M.; Namaei, M.H. Green synthesis of silver nanoparticles using aqueous extract of saffron (Crocus sativus L.) wastages and its antibacterial activity against six bacteria. Asian Pac. J. Trop. Biomed. 2017, 7, 227–233. [Google Scholar] [CrossRef]
- Gomathi, M.; Rajkumar, P.V.; Prakasam, A.; Ravichandran, K. Green synthesis of silver nanoparticles using Datura stramonium leaf extract and assessment of their antibacterial activity. Resour. Effic. Technol. 2017, 3, 280–284. [Google Scholar] [CrossRef]
- Singh, A.; Mittal, S.; Shrivastav, R.; Dass, S.; Srivastava, J.N. Biosynthesis of silver nanoparticles using Ricinus communis L. Leaf extract and its antibacterial activity. Dig. J. Nanomater. Biostructures 2012, 7, 1157–1163. [Google Scholar]
- Maqbool, Q.; Iftikhar, S.; Nazar, M. Green fabricated CuO nanobullets via Olea europaea leaf extract shows auspicious antimicrobial potential. IET Nanobiotechnol. 2017, 11, 463–468. [Google Scholar] [CrossRef]
- Shende, S.; Ingle, A.P.; Gade, A.; Rai, M. Green synthesis of copper nanoparticles by Citrus medica Linn. (Idilimbu) juice and its antimicrobial activity. World J. Microbiol. Biotechnol. 2015, 31, 865–873. [Google Scholar] [CrossRef]
- Ashraf, J.M.; Ansari, M.A.; Khan, H.M. Green synthesis of silver nanoparticles and characterization of their inhibitory effects on AGEs formation using biophysical techniques. Sci. Rep. 2016, 6, 20414. [Google Scholar] [CrossRef] [PubMed]
- Shankar, S.; Ahmad, A.; Sastry, M. Geranium leaf assisted biosynthesis of silver nanoparticles. Biotechnol. Prog. 2003, 19, 1627–1631. [Google Scholar] [CrossRef] [PubMed]
- Gaffet, E.; Tachikart, M.; El Kedim, O.; Rahouadj, R. Nanostructural materials formation by mechanical alloying: Morphologic analysis based on transmission and scanning electron microscopic observations. Mater. Charact. 1996, 36, 185–190. [Google Scholar] [CrossRef]
- Amulyavichus, A.; Daugvila, A.; Davidonis, R.; Sipavichus, C. Study of chemical composition of nanostructural materials prepared by laser cutting of metals. Fizika Met. Met. 1998, 85, 111–117. [Google Scholar]
- Thirumalai, V.A.; Prabhu, D.; Soniya, M. Stable silver nanoparticle synthesizing methods and its applications. J. Biol. Sci. Res. 2010, 1, 259–270. [Google Scholar]
- Zhu, J.; Liao, X.; Chen, H.Y. Electrochemical preparation of silver dendrites in the presence of DNA. Mater. Res. Bull. 2001, 36, 1687–1692. [Google Scholar] [CrossRef]
- Salkar, R.A.; Jeevanandam, P.; Aruna, S.T.; Koltypin, Y.; Gedanken, A. The sonochemical preparation of amorphous silver nanoparticles. J. Mater. Chem. 1999, 9, 1333–1335. [Google Scholar] [CrossRef]
- Mandal, S.; Arumugam, S.; Pasricha, R.; Sastry, M. Silver nanoparticles of variable morphology synthesized in aqueous foams as novel templates. Bull. Mater. Sci. 2001, 28, 503–510. [Google Scholar] [CrossRef]
- Rolim, W.R.; Pelegrino, M.T.; de Araújo Lima, B.; Ferraz, L.S.; Costa, F.N.; Bernardes, J.S.; Rodigues, T.; Brochi, M.; Seabra, A.B. Green tea extract mediated biogenic synthesis of silver nanoparticles: Characterization, cytotoxicity evaluation and antibacterial activity. Appl. Surf. Sci. 2019, 463, 66–74. [Google Scholar] [CrossRef]
- Scherer, M.D.; Sposito, J.C.; Falco, W.F.; Grisolia, A.B.; Andrade, L.H.; Lima, S.M.; Machado, G.; Nascimento, V.A.; Daniel, A.G.; Heberton, W.; et al. Cytotoxic and genotoxic effects of silver nanoparticles on meristematic cells of Allium cepa roots: A close analysis of particle size dependence. Sci. Total Environ. 2019, 660, 459–467. [Google Scholar] [CrossRef]
- Geetha, R.; Ashokkumar, T.; Tamilselvan, S. Green synthesis of gold nanoparticles and their anticancer activity. Cancer Nano 2013, 4, 91–98. [Google Scholar] [CrossRef] [PubMed]
- Rozalen, M.; Sánchez, M.; Fernández, M.; Widmann, T.J.; Rivera, J. Synthesis of controlled-size silver nanoparticles for the administration of methotrexate drug and its activity in colon and lung cancer cells. RSC Adv. 2020, 10, 10646–10660. [Google Scholar] [CrossRef]
- Gomathi, A.C.; Rajarathinam, S.X.; Sadiq, A.M.; Rajeshkumar, S. Anticancer activity of silver nanoparticles synthesized using aqueous fruit shell extract of Tamarindus indica on MCF-7 human breast cancer cell line. J. Drug Deliv. Sci. Technol. 2020, 55, 101376. [Google Scholar] [CrossRef]
- Salem, W.; Leitner, D.R.; Zingl, F.G. Antibacterial activity of silver and zinc nanoparticles against Vibrio cholerae and enterotoxic Escherichia coli. Int. J. Med. Microbiol. 2015, 305, 85–95. [Google Scholar] [CrossRef]
- Wang, L.; Hu, C. The antimicrobial activity of nanoparticles: Present situation and prospects for the future. Int. J. Nanomed. 2013, 12, 1227–1249. [Google Scholar] [CrossRef]
- Elumalai, K.; Velmurugan, S. Green synthesis, characterization and antimicrobial activities of Zinc Oxide nanoparticles from the leaf extract of Azadirachta indica (L.). Appl. Surf. Sci. 2015, 345, 329–336. [Google Scholar] [CrossRef]
- Cardeño, L.; Londoño, M.E. Síntesis verde de nanopartículas de plata mediante el uso del ajo (Allium sativum). Revista Soluciones de Postgrado EIA 2014, 12, 129–140. [Google Scholar]
- Ledezma, A.; Romero, J.; Hernández, M.; Moggio, I.; Arias, E.; Padrón, G. Síntesis biomimética de nanopartículas de plata utilizando extracto acuoso de nopal (Opuntia sp.) y su electrohilado polimérico. Superficies y Vacío 2014, 27, 133–140. [Google Scholar]
- Sulaiman, G.M.; Mohammed, W.H.; Marzoog, T.R.; Al-Amiery, A.A.A.; Kadhum, A.A.H.; Mohamad, A.B. Green synthesis, antimicrobial and cytotoxic effects of silver nanoparticles using Eucalyptus chapmaniana leaves extract. Asian Pac. J. Trop. Biomed. 2013, 3, 58–63. [Google Scholar] [CrossRef]
- Haytham, M.M.I. Green synthesis and characterization of silver nanoparticles using banana peel extract and their antimicrobial activity against representative microorganisms. J. Radiat. Res. Appl. Sci. 2015, 8, 265–275. [Google Scholar]
- Mittal, A.; Chisti, Y.; Banerjee, U. Synthesis of metallic nanoparticles using plant extracts. Biotechnol. Adv. 2013, 31, 346–356. [Google Scholar] [CrossRef] [PubMed]
- Fayaz, A.; Balaji, K.; Girilal, M. Biogenic synthesis of silver nanoparticles and their synergistic effect with antibiotics: A study against gram-positive and gram-negative bacteria. Nanomed. Nanotechnol. Biol. Med. 2010, 6, 103–109. [Google Scholar] [CrossRef] [PubMed]
- Martínez, J.C.; Chequer, N.A.; González, J.L.; Cordova, T. Alternative methodology for gold nanoparticles diameter characterization using PCA technique and UV-VIS spectrophotometry. Nanosci. Nanotechnol. 2012, 2, 184–189. [Google Scholar] [CrossRef]
- Smitha, S.L.; Nissamudeen, K.M.; Philip, D.; Gopchandran, K.G. Studies on surface plasmon resonance and photoluminescence of silver nanoparticles. Spectrochim. Acta Part A Mol. Biomol. Spectrosc. 2008, 71, 186–190. [Google Scholar] [CrossRef]
- Amanchy, R. Phytofabrication of silver nanoparticles using Myriostachya wightiana as a novel bioresource, and evaluation of their biological activities. Braz. Arch. Biol. Technol. 2017, 60. [Google Scholar] [CrossRef]
- Creighton, J.; Blatchford, C.; Albrecht, M. Plasma resonance enhancement of Raman scattering by pyridine adsorbed on silver or gold sol particles of size comparable to the excitation wavelength. J. Chem. Soc. Faraday Trans. II 1979, 75, 790–798. [Google Scholar] [CrossRef]
- Patakfalvi, R.; Oszko, A.; Dekany, I. Synthesis and characterization of silver nanoparticle/kaolinite composites. Colloids Surf. A Physicochem. Eng. Asp. 2013, 220, 45–54. [Google Scholar] [CrossRef]
- Elizondo, N.; Segovia, P.; Coello, V.; Torres, E. Green Synthesis and Characterizations of Silver and Gold Nanoparticles. In Green Chemistry-Environmentally Benign Approaches; Kidwai, M., Ed.; Intech: Rijeka, Croatia, 2012; pp. 139–156. [Google Scholar]
- Green, D.; Jayasundara, S.; Lam, Y.; Harris, M. Chemical reaction kinetics leading to the first Stober silica nanoparticles–NMR and SAXS investigation. J. Non-Cryst. Solids 2003, 315, 166–179. [Google Scholar] [CrossRef]
- Khan, M.; Khan, M.; Adil, S. Green synthesis of silver nanoparticles mediated by Pulicaria glutinosa extract. Int. J. Nanomed. 2013, 8, 1507–1516. [Google Scholar]
- Chhatre, A.; Solasa, P.; Sakle, S.; Thaokar, R.; Mehra, A. Color and surface plasmon effects in nanoparticle systems: Case of silver nanoparticles prepared by microemulsion route. Colloids Surf. A Physicochem. Eng. Asp. 2012, 404, 83–92. [Google Scholar] [CrossRef]
- Annamalai, J.; Nallamuthu, T. Green synthesis of silver nanoparticles: Characterization and determination of antibacterial potency. Appl. Nanosci. 2016, 6, 259–265. [Google Scholar] [CrossRef] [PubMed]
- Abdel-Fattah, W.I.; Abdelsattar, A.; Nagwa, A.; Salama, E.; Maghraby, A.; Ghareib, W. Functionality, antibacterial efficiency and biocompatibility of nanosilver/chitosan/silk/phosphate scaffolds 1. Synthesis and optimization of nanosilver/chitosan matrices through gamma rays irradiation and their antibacterial activity. Mater. Res. Express 2014, 1, 035024. [Google Scholar] [CrossRef]
- Diantoro, M.; Fitrianingsih, R.; Mufti, N.; Fuad, A. Synthesis of silver nanoparticles by chemical reduction at various fraction of MSA and their structure characterization. AIP Conf. Proc. 2014, 257, 1589. [Google Scholar]
- Virgen-Ortiz, A.; Limón-Miranda, S.; Soto-Covarrubias, M.; Apolinar-Iribe, A.; Rodríguez-León, E.; Iñiguez-Palomares, R. Biocompatible silver nanoparticles synthesized using rumex hymenosepalus extract decreases fasting glucose levels in diabetic rats. Dig. J. Nanomater. Biostruc. 2015, 10, 927–933. [Google Scholar]
- Chakraborty, I.; Carvalho, D.; Shirodkar, S.N.; Lahiri, S.; Bhattacharyya, S.; Banerjee, R.; Waghmare, U.; Ayyub, P. Novel hexagonal polytypes of silver: Growth, characterization and first-principles calculations. J. Phys. Condens. Matter 2011, 23, 325401. [Google Scholar] [CrossRef]
- Leite, M.S.; Rodrigues, V.; Zanchet, D. Structural effects on Au and Ag colloidal nanoparticles. Progr. Colloid Polym. Sci. 2004, 128, 131–134. [Google Scholar]
- Sadaiyandi, K. Size dependent Debye temperature and mean square displacements of nanocrystalline Au, Ag and Al. Mater. Chem. Phys. 2009, 115, 703–706. [Google Scholar] [CrossRef]
- Prasad, P.S.; Bilal, A.S. Structural Studies of Silver Nanoparticles Obtained Through Single-Step Green Synthesis. IOP Conf. Ser. Mater. Sci. Eng. 2015, 92, 012004. [Google Scholar]
- Qi, W.H.; Wang, M.P. Size and shape dependent lattice parameters of metallic nanoparticles. J. Nanoparticle Res. 2005, 7, 51–57. [Google Scholar] [CrossRef]
- Cui, D.H.; Zheng, Y.F.; Song, X.C. A novel visible-light-driven photocatalyst Ag2O/AgI with highly enhanced photocatalytic performances. J. Alloys Compd. 2017, 701, 163–169. [Google Scholar] [CrossRef]
- McFarland, J. Nephelometer: An instrument for media used for estimating the number of bacteria in suspensions used for calculating the opsonic index and for vaccines. J. Am. Med. Assoc. 1907, 14, 1176–1178. [Google Scholar] [CrossRef]
- Huang, Z.; Hu, Y.; Shou, S.; Song, M. Isolation and partial characterization of cyclic lipopeptide antibiotics produced by Paenibacillus ehimensis B7. BMC Microbiol. 2013, 13, 87. [Google Scholar] [CrossRef] [PubMed]
- Sethuraman, P.; Balasubramanian, N. Removal of Cr(VI) from aqueous solution using Bacillus subtilis, Pseudomonas aeruginosa and Enterobacter cloacae. Int. J. Eng. Sci. Technol. 2010, 2, 1811–1825. [Google Scholar]
- Olvera, C.; Alexandra, D. Evaluación del Efecto Antimicrobiano de las Nanopartículas de Plata Sintetizadas por Paecilomyces variotii. Master’s Thesis, Instituto Politécnico Nacional, Mexico City, Mexico, 2017. [Google Scholar]
- Flores, C.Y. Nanopartículas de Plata con Potenciales Aplicaciones en Materiales Implantables: Síntesis, Caracterización Fisicoquímica y Actividad Bactericida. Ph.D. Thesis, Instituto de Investigaciones Fisicoquímicas Teóricas y Aplicadas, Univesidad Nacional de la Plata, La Plata, Argentina, 2014. [Google Scholar]
- Martínez, F. Evaluación de la Toxicidad de Nanopartículas de Plata y Dióxido de Titanio en Procariotas y Eucariotas. Ph.D. Thesis, Energías Renovables y Protección del Medio Ambiente, CIMAV, Chihuahua, Mexico, 2015. [Google Scholar]
- Saba, H. A Review on Nanoparticles: Their Synthesis and Types. Res. J. Recent. Sci. 2015, 4, 1–3. [Google Scholar]
- Yan, X.; Bin, H.; Lihong, L. Antibacterial mechanism of silver nanoparticles in Pseudomonas aeruginosa: Proteomics approach. Metallomics 2018, 10, 557–564. [Google Scholar] [CrossRef]

| McFarland Number | Approximate Cell Number in Suspension [CFU */mL] | Approximate Cell Number in Biofilm [CFU */mL] |
|---|---|---|
| 0.5 | 1.5 × 108 | 5.0 × 106 |
| 1.0 | 3.0 × 108 | 1.0 × 107 |
| 2.0 | 6.0 × 108 | 2.0 × 107 |
| 3.0 | 9.0 × 108 | 3.0 × 107 |
| AgNPs Concentration (μg/mL) | Average Cell Concentration (CFU/mL) | ||
|---|---|---|---|
| 0 h | 2 h | 4 h | |
| 0.36 | 0 | 0 | 0 |
| 0.18 | 300.7 ± 168.8 | 38.8 ± 18.4 | 16.8 ± 18.0 |
| 0.09 | 1032.8 ± 196.9 | 403.0 ± 282.7 | 326.2 ± 135.6 |
| 0.05 | 1500 ± 0 | 900 ± 138.5 | 705 ± 26.3 |
| Reference | Conditions | Particle Size (nm) | MIC (μg/mL) |
|---|---|---|---|
| This work | 35 °C, 4 h | 50 ± 2.5 | 0.18 |
| Olvera, et al. [67] | 37 °C, 4 h | 10.32 | 10 |
| Olvera, et al. [67] | 37 °C, 4 h | 9.53 | 5 |
| Flores, [68] | 35 °C, 4 h | 6 ± 2 | 5.3 |
| Martinez, [69] | 35 °C, 6 h | 24.4 ± 9 | 0.4 |
| AgNPs Concentration (μg/mL) | Average Inhibition Halos (cm) |
|---|---|
| 0.72 | 1.08 ± 0.2 |
| 0.36 | 0.96 ± 0.05 |
| 0.18 | 0.85 ± 0.04 |
| 0.09 | 0.75 ± 0.04 |
| 0.05 | 0.68 ± 0.03 |
© 2020 by the authors. Licensee MDPI, Basel, Switzerland. This article is an open access article distributed under the terms and conditions of the Creative Commons Attribution (CC BY) license (http://creativecommons.org/licenses/by/4.0/).
Share and Cite
Martínez Espinosa, J.C.; Carrera Cerritos, R.; Ramírez Morales, M.A.; Sánchez Guerrero, K.P.; Silva Contreras, R.A.; Macías, J.H. Characterization of Silver Nanoparticles Obtained by a Green Route and Their Evaluation in the Bacterium of Pseudomonas aeruginosa. Crystals 2020, 10, 395. https://doi.org/10.3390/cryst10050395
Martínez Espinosa JC, Carrera Cerritos R, Ramírez Morales MA, Sánchez Guerrero KP, Silva Contreras RA, Macías JH. Characterization of Silver Nanoparticles Obtained by a Green Route and Their Evaluation in the Bacterium of Pseudomonas aeruginosa. Crystals. 2020; 10(5):395. https://doi.org/10.3390/cryst10050395
Chicago/Turabian StyleMartínez Espinosa, Juan Carlos, Raúl Carrera Cerritos, Maria Antonieta Ramírez Morales, Karla Paola Sánchez Guerrero, Rocio Alejandra Silva Contreras, and Juan H. Macías. 2020. "Characterization of Silver Nanoparticles Obtained by a Green Route and Their Evaluation in the Bacterium of Pseudomonas aeruginosa" Crystals 10, no. 5: 395. https://doi.org/10.3390/cryst10050395
APA StyleMartínez Espinosa, J. C., Carrera Cerritos, R., Ramírez Morales, M. A., Sánchez Guerrero, K. P., Silva Contreras, R. A., & Macías, J. H. (2020). Characterization of Silver Nanoparticles Obtained by a Green Route and Their Evaluation in the Bacterium of Pseudomonas aeruginosa. Crystals, 10(5), 395. https://doi.org/10.3390/cryst10050395

